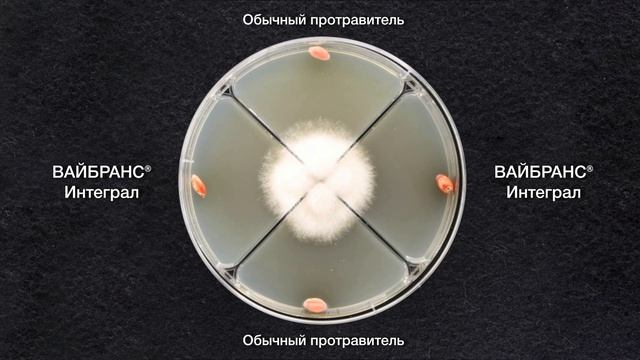
Фузариозные корневые гнили злаковых культур смотреть онлайн

Автор / Канал: Строительные Мнения Страница 4

Бесконтактный диспенсер антисептика Dezapparat.ru

Ламинат Kastamonu Sunfloor.

Денежное дерево. Обзор деревьев.

ЖИЛА ЖЕЛЕЗА НОВАЯ СТРУКТУРА - Обзор снапшота 21w16a майнкрафта 1.17/1.18

Обзор на инверторные сплит-системы PERFETTO от ROYAL Clima

Коврик для компьютерной мыши СВОИМИ РУКАМИ .

Как ДЕШЕВО украсить фасад дома? Скала в отделке загородного коттеджа. Строительство в Красноярске

Ингрид F1 перец MoravoSeed Антифейк

измельчитель травы / chopper grass

Тканевый навес от солнца Patio

Дверь металлическая входная ДС4

Видеоматериал Живая и неживая природа
Фузариозные корневые гнили злаковых культур

Как не стать жертвой оферистов при передачи ксерокопии паспорта третьим лицам

Как снять транспондер с держателя.

ПЛИТКА ДЛЯ ВАННОЙ КЕРАМИН РОМАНА

Весенняя обрезка плющелистной пеларгонии (герани).

Автономный пожарный датчик с передатчиком 433МГц с aliexpress!

Prio Новая вода OD360

Мандарин абхазский ранний

777dveri.ru Омск Ампир ДО каштан 2 межкомнатная дверь

100/20 печь для теплиц и не только. Как самому сделать печку?

Ресторан Prestonfield в Эдинбурге-особняк 17 века, где ели короли. И где бы ели враги Джеймса Бонда

Кованая мебель на заказ, быстро качественно не дорого.
За каждым успешным каналом стоит личность, идея и сотни часов кропотливого труда. Если вы здесь, значит, автор «Строительные Мнения» уже сумел зацепить ваше внимание своим уникальным стилем или подачей. А мы на RUVIDEO позаботились о том, чтобы вы могли изучить весь архив его работ в максимально комфортных условиях — без лишней суеты и преград.
Почему за работами канала «Строительные Мнения» так интересно наблюдать? Всё просто: это честный контент, который находит отклик в сердцах зрителей. На нашем ресурсе вы можете смотреть онлайн все видео любимого автора бесплатно и в хорошем качестве. Нам важно, чтобы вы видели каждую деталь и слышали каждый нюанс, поэтому мы используем только стабильные плееры из открытых источников Rutube.
Следите за новинками канала, пересматривайте старые шедевры и открывайте для себя новые грани творчества «Строительные Мнения». Мы постоянно обновляем ленту, чтобы у вас под рукой всегда были самые свежие выпуски. Никаких сложных регистраций — только вы и творчество, которое вдохновляет. Приятного вам путешествия по миру авторского контента на RUVIDEO!
Видео взято из открытых источников Rutube. Если вы правообладатель, обратитесь к первоисточнику.